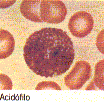
eosinófilo
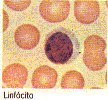
linfócito
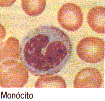
: : :  monócito  : : :
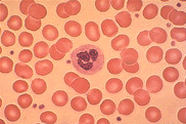
: : :  hemácias normais com um neutrófilo no centro e plaquetas (pequenas) espalhadas  : : :
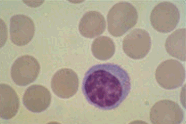
: : :  esferocitose - hemácias pequenas e diminuídas translúcidas  : : :
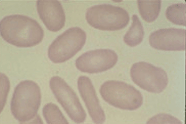
: : :  eliptocitose ou ovalocitose  : : :
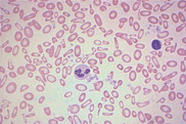
: : :  hipocromia, anisocitose e poiquilocitose  : : :

Funcionamento
Em anatomia e fisiologia, o sistema circulatório é percorrido pelo sangue através das artérias, dos capilares e das veias. Este trajeto começa e termina no coração. O aparelho circulatório é responsável pelo fornecimento de oxigênio, substâncias nutritivas e hormônios aos tecidos; além disso, também exerce a função de transportar os produtos finais do metabolismo (excretas como CO2 e uréia) até os órgãos responsáveis por sua eliminação.
A circulação inicia-se no princípio da vida fetal. Calcula-se que uma porção determinada de sangue complete seu trajeto em um período aproximado de um minuto.
Vasos sanguíneos
Os vasos sanguíneos são tubos pelo qual o sangue circula. Há três tipos principais: as artérias, que levam sangue do coração ao corpo; as veias, que o reconduzem ao coração; e os capilares, que ligam artérias e veias. Num circulo completo, o sangue passa pelo coração duas vezes: primeiro rumo ao corpo; depois rumo aos pulmões.

Coração (o centro funcional)
O aparelho circulatório é formado por um sistema fechado de vasos sanguíneos, cujo centro funcional é o coração. O coração bombeia sangue para todo o corpo através de uma rede de vasos. O sangue transporta oxigênio e substâncias essenciais para todos os tecidos e remove produtos residuais desses tecidos.
O coração é formado por quatro cavidades; as aurículas direita e esquerda e os ventrículos direito e esquerdo. O lado direito do coração bombeia sangue carente de oxigênio, procedente dos tecidos, para os pulmões, onde este é oxigenado. O lado esquerdo do coração recebe o sangue oxigenado dos pulmões, impulsionando-os, através das artérias, para todos os tecidos do organismo.
O sangue procedente de todo o organismo chega à aurícula direita através de duas veias principais; a veia cava superior e a veia cava inferior. Quando a aurícula direita se contrai, impulsiona o sangue através de um orifício até o ventrículo direito. A contração deste ventrículo conduz o sangue para os pulmões, onde é oxigenado. Depois, ele regressa ao coração na aurícula esquerda. Quando esta cavidade se contrai, o sangue passa para o ventrículo esquerdo e dali, para a aorta, graças à contração ventricular.
Ramificações
As artérias menores dividem-se em uma fina rede de vasos ainda menores, os chamados capilares. Deste modo, o sangue entra em contato estreito com os líquidos e os tecidos do organismo. Nos vasos capilares, o sangue desempenha três funções; libera o oxigênio para os tecidos, proporciona os nutrientes às células do organismo, e capta os produtos residuais dos tecidos. Depois, os capilares se unem para formar veias pequenas. Por sua vez, as veias se unem para formar veias maiores, até que por último, o sangue se reúne na veia cava superior e inferior e conflui para o coração, completando o circuito.
Circulação portal
A circulação portal é um sistema auxiliar do sistema nervoso. Um certo volume de sangue procedente do intestino é transportado para o fígado, onde ocorrem mudanças importantes no sangue, incorporando-o à circulação geral até a aurícula direita.
Coração

No homem, a circulação é feita através de um sistema fechado de vasos sanguíneos, cujo centro funcional é o coração.
O coração é um órgão musculoso oco, o miocárdio, com fibras estriadas, revestido externamente pelo pericárdio (serosa). O coração é do tamanho aproximado de um punho fechado e com peso em média de 400 g, tem cerca de 12 cm de comprimento por 8 a 9 cm de largura. O coração quase sempre continua a crescer em massa e tamanho até um período avançado da vida; este aumento pode ser patológico.
Localização e funcionamento
Ele se localiza no meio do peito, sob o osso esterno, ligeiramente deslocado para a esquerda. Ocupa no tórax, a região conhecida como mediastino médio. O coração funciona como uma bomba, recebendo o sangue das veias e impulsionando-o para as artérias.
Divisão do coração
O coração é dividido por um septo vertical em duas metades. Cada metade é formada de duas câmaras; uma aurícula superior e um ventrículo inferior. Entre cada câmara há uma válvula, a tricúspide do lado direito, e a bicúspide do lado esquerdo. Estas válvulas abrem-se em direção dos ventrículos, durante a contração das aurículas. Na aurícula direita chegam as veias cava superior e inferior, e na aurícula esquerda, as quatro veias pulmonares. Do ventrículo direito sai a artéria pulmonar e do ventrículo esquerdo sai a artéria aorta.

Estrutura e funções
A atividade do coração consiste na alternância da contração (sístole) e do relaxamento (diástole) das paredes musculares das aurículas e ventrículos. Durante o período de relaxamento, o sangue flui das veias para as duas aurículas, dilatando-as de forma gradual. Ao final deste período, suas paredes se contraem e impulsionam todo o seu conteúdo para os ventrículos.
A sístole ventricular segue-se imediatamente a sístole auricular. A contração ventricular é mais lenta e mais energética. As cavidades ventriculares se esvaziam quase que por completo com cada sístole, depois, o coração fica em um completo repouso durante um breve espaço de tempo. A freqüência cardíaca normal é de 72 batimentos por minuto, em situação de repouso.
Para evitar que o sangue, impulsionado dos ventrículos durante a sístole, reflua durante a diástole, há válvulas localizadas junto aos orifícios de abertura da artéria aorta e da artéria pulmonar, chamadas válvulas semilunares. Outras válvulas que impedem o refluxo do sangue são a válvula tricúspide, situada entre a aurícula e o ventrículo direito, e a válvula bicúspide ou mitral, entre a aurícula e o ventrículo esquerdo.
A freqüência das batidas do coração é controlada pelo sistema nervoso vegetativo, de modo que o simpático a : : : coração doente : : :acelera e o sistema parassimpático a retarda.
Doenças do coração
As doenças cardíacas são as principais causas de mortalidade nos países desenvolvidos. Podem ocorrer em conseqüência de defeitos congênitos, infecções, estreitamento das artérias coronárias, hipertensão ou alterações no ritmo cardíaco.
A principal forma de doença cardíaca nos países ocidentais é a arteriosclerose. O acúmulo de depósito de material lipídico – colesterol – pode causar uma obstrução que tampa as artérias (trombose). Esta é a causa mais importante de um ataque cardíaco, ou infarto do miocárdio, que tem conseqüências mortais com freqüência .
A alteração do ritmo cardíaco normal (arritmia) é a causa imediata de morte em muitos infartos do miocárdio.
O problema mais grave é o bloqueio cardíaco completo. Este pode ser corrigido pela implantação de um marcapasso artificial (um dispositivo que emite descargas elétricas rítmicas), para provocar a contração regular do músculo cardíaco.
Eletrocardiograma
Um Eletrocardiograma (ECG) registra a atividade elétrica do coração. Um impulso elétrico, gerado no nódulo sino-auricular, precede cada contração do músculo cardíaco; as ondas desenhadas em um ECG traçam o trajeto desses impulsos tal como se propagam no coração. As irregularidades do ECG refletem afecções no músculo, no fornecimento de sangue ou no controle neural do coração.
Sangue
Definição
O sangue é uma substância líquida que circula pelas artérias e veias do organismo. Em uma pessoa normal sadia, cerca de 45% do volume de seu sangue são células (a maioria de glóbulos vermelhos, glóbulos brancos e plaquetas). O sangue é vermelho brilhante, quando oxigenado nos pulmões (nos alvéolos pulmonares). Ele adquire uma tonalidade mais azulada, quando perde seu oxigênio, através das veias e dos pequenos vasos denominados capilares. Este movimento circulatório do sangue ocorre devido à atividade coordenada do coração, pulmões e das paredes dos vasos sanguíneos. O sangue transporta ainda muitos sais e substâncias orgânicas dissolvidas.
No interior de muitos ossos, há cavidades preenchidas por um tecido macio, a medula óssea vermelha, onde são produzidas as células do sangue: hemácias, leucócitos e plaquetas.
Respiração

Plaquetas
As plaquetas são pequenas massas protoplásticas anucleares, que aderem à superfície interna da parede dos vasos sanguíneos no lugar de uma lesão e fecham o defeito da parede vascular. Tem cerca de 200.000 a 300.000 plaquetas, denominadas trombócitos, no sangue.
Glóbulos Brancos
No sangue, temos de 5.000 a 10.000 corpúsculos ou glóbulos brancos (células brancas do sangue), que recebem o nome de leucócitos. De 4.000 a 11.000 glóbulos brancos por mm3. São de vários tipos principais:
Neutrófilos – Que fagocitam e destroem bactérias;
Eosinófilos – Que aumentam seu número e se ativam na presença de certas infecções e alergias;
Basófilos – Que segregam substâncias como a heparina, de propriedades anticoagulantes, e a histamina;
Linfócitos – Que desempenham um papel importante na produção de anticorpos e na imunidade celular;
Monócitos – Que digerem substâncias estranhas não bacterianas.
.

Doenças Sanguíneas
As doenças do sangue resultam mudanças anormais em sua composição. A redução anômala do conteúdo de hemoglobina ou do número de glóbulos vermelhos é conhecida como anemia. A formação de hemoglobina anômala é característica da anemia falciforme e da talassemia. A leucemia é acompanhada por uma proliferação desordenada de leucócitos.
A deficiência de qualquer dos fatores necessários à coagulação do sangue provoca hemorragias. Diversas doenças hemorrágicas, como a hemofilia, são hereditárias.
Anemia
Introdução
“Anemia”, palavra que do grego significa “privação de sangue”. É caracterizada por uma diminuição da quantidade total do número de glóbulos vermelhos ou de hemoglobina do sangue (concentração de hemoglobina inferior a 0,13g/ml no homem e a 0,12g/ml na mulher).
Hemoglobina
A hemoglobina é constituída por um pigmento vermelho chamado heme, que dá a cor vermelha característica do sangue. É um pigmento especial predominante no sangue, cuja função é transportar o oxigênio. Transporta o oxigênio dos pulmões até os tecidos do corpo. Depois, inverte sua função e recolhe o dióxido de carbono, transportando-o até os pulmões para ser expirado.
A deficiência de hemoglobina provoca a anemia. As alterações da estrutura da hemoglobina podem causar a anemia falciforme.
Anemia das células falciformes
A anemia falciforme é um processo hereditário em que a hemoglobina apresenta-se alterada. Conhecida também como anemia drepanocítica, é causada pela existência de hemoglobina anômala ou hemoglobina S, que muda de forma quando a quantidade de oxigênio no sangue se reduz por qualquer motivo. As hemácias que contêm a hemoglobina também mudam, adotando a forma de foice (falciforme).

hemácias falciforme
Outros tipos de anemia
Pode-se verificar a anemia em diversos casos patológicos: hemólise, doenças malignas, saturnismo, talassemia, hemorragia, deficiência de vitamina B12, deficiência de ferro, afecções inflamatórias crônicas, etc.
A mais comum é a anemia ferropênica provocada por um déficit de ferro, elemento essencial para a fabricação de glóbulos vermelhos. A anemia perniciosa é provocada por um déficit de vitamina B12, fundamental para a produção de hemácias.
Análise de sangue
Através da análise de sangue, verifica-se a definição das diferentes formas de anemia e determina a sua causa. Destinguem-se:
- Segundo o volume globular médio (hemácias), as anemias microcíticas, normocíticas, macrocíticas e megalocíticas;
- Segundo a concentração corpuscular média de hemoglobina (cromia), anemias hipocrônicas ou normocrônicas;
- Segundo a concentração sérica de ferro e de siderofilina, as anemias hipo, normo ou hipersiderêmicas com siderofilina baixa, normal ou aumentada;
- Segundo o aspecto da medula óssea, as formas megaloblásticas;
- Número de reticulócitos do sangue circulante, as anemias arregenerativas ou regenerativas;
Composição do Sangue
O sangue é formado por um líquido amarelado denominado plasma, no qual se encontram em suspensão milhões de células.
Entre as proteínas plasmáticas, encontram-se a albumina, responsável pela manutenção da pressão osmótica sanguínea; o fibrinogênio e a protombina, que participam na coagulação; e as globulinas, incluindo os anticorpos, proporcionam imunidade face a muitas doenças.
Uma grande parte do plasma (95%) é composta pela água, meio que facilita a circulação de muitos fatores indispensáveis que formam o sangue.

O nível de sal no plasma é semelhante ao nível de sal na água do mar.
Na figura acima, pode-se observar um vaso sanguíneo (cortado ao meio), onde aparecem os elementos figurados (plaquetas, glóbulos vermelhos e brancos), suspensos sobre o plasma sanguíneo.
Elementos Figurados
- Glóbulos vermelhos
- Glóbulos brancos
- Plaquetas
Glóbulos vermelhos
Introdução
Os glóbulos vermelhos são corpúsculos vermelhos do sangue. Um milímetro cúbico do sangue contém cerca de cinco milhões de corpúsculos ou glóbulos vermelhos, chamados também de eritrócitos ou hemácias. Uma variação de 4 a 6 milhões é considerada normal e uma de 8 milhões pode ser encontrada em indivíduos que vivem em regiões de grande altitude. Esse número pode ser menor que 1 milhão em caso de anemia grave. Os glóbulos vermelhos contêm hemoglobina.
Veja abaixo um esquema geral das principais alterações morfo-fisiológicas dos eritrócitos:: : : internet : : :
.
Eritrócitos Normais
A imagem abaixo mostra um esfregaço de sangue em lâmina de vidro observado em microscópio sob objetiva de imersão a óleo. Observa-se eritrócitos (hemácias) normocrômicas indicando boa saturação de hemoglobina. No centro, observamos um neutrófilo segmentado. As estruturas menores, densas, são as plaquetas.
,Eritrócitos Normais
Através do exame do esfregaço sanguíneo em lâmina de vidro observado em microscópio sob objetiva de imersão a óleo, podemos observar alterações de forma e tamanho, importantes para caracterizar desde deficiências, como a hipocromia e microcitose da anemia carencial, como a macrocitose da carência da vitamina B12 e do acido fólico, como a esferocitose, eliptocitose e drepanocitose das anemias congênitas.
Drepanocitose
Bastante comum no Brasil devido a alta prevalência na raça negra, a Anemia Falciforme é caracterizada pela existência de hemácias falciformes (em forma de foice) ou drepanócito.

Drepanocitose
Esferocitose e Eliptocitose
A esferocitose congênita é caracterizada por um esfregaço em que as hemácias são pequenas e redondas: esferócitos, ocorrendo na anemia hemolítica por exemplo. Neste esfregaço ainda observamos um linfócito normal.
Na eliptocitose as hemácias são alongadas ou ovais, ocorrendo em diversas formas de anemia e anomalias.

Esferocitose Eliptocitose
Hipocromia e Microcitose
A imagem mostra uma intensa hipocromia caracterizada pelo descoramento das hemácias que se apresentam com o centro pálido. A microcitose (hemácias de tamanho pequeno), e a acentuada anisocitose (variação muito grande no tamanho das hemácias) e poiquilocitose (variação quanto a forma), caracterizam uma grave anemia por deficiência de ferro.
Hipocromia, Anisocitose e Poiquilocitose
Doação de sangue
| Grupos compatíveis Obs.: Sangue negativo só recebe negativo. |
Sangue Tipo:
Recebe Tipo:
A+
A–
B+
B–
AB+
AB–
O+
O–A+ ou A– ou O–
A– ou O–
B+ ou B– ou O–
B– ou O–
AB+ ou AB– ou O–
AB– ou O–
O+ O–
O–










